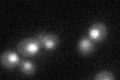
YLR430W
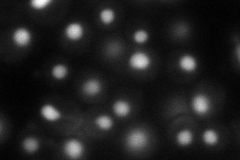
YLR430W
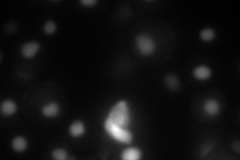
YLR430W
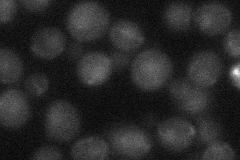
YLR430W
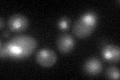
YLR430W

View description
Presumed helicase required for RNA polymerase II transcription termination and processing of RNAs; homolog of Senataxin which causes Ataxia-Oculomotor Apraxia 2 and a dominant form of amyotrophic lateral sclerosis
Localization:
Intensity:
Fold change:
Significance:
-
C’ GFP library in SD
nucleus27.89 -
N' NOP1pr-GFP in SD
nucleus89.9328 -
N' TEF2pr-mCherry in SD
nucleus62.6787 -
N' NATIVEpr-GFP in SD
below threshold21.1119 -
N' TEF2pr-VC and Cyto-VN in SD

nucleus36.31 -
C’ GFP library in SD+DTT
nucleus22.880.82No -
C’ GFP library in SD+H2O2

nucleus28.821.03No -
C’ GFP library in Starvation Media

nucleus18.360.65Yes -
C’ GFP library on the background of Pup2-DaMP

nucleus -
C’ GFP library on the background of CCT mutant

nucleus34.52721.23771No
